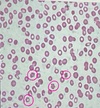

Objetivos de la nefrona (6)
- Homeostasis del medio interno
- Mantener osmolaridad
- Mantener equilibrio ácido base
- Filtración de sangre circulante (ultrafiltrado)
- Reabsorción selectiva
- Secreción selectiva
Unidad funcional del riñón
Nefrona
Componentes de la nefrona
Corpúsculo renal
- Glomérulo: penacho glomerular y arteriola aferente
- Cápsula de Bowman
Túbulo proximal distal
Composición de las arteriolas glomerulares
Arteriola aferente → glomérulo → arteriola eferente

¿Qué forma la arteriola eferente?
Segunda red capilar alrededor del túbulo: capilares peritubulares
En las nefronas yuxtamedulares, ¿cómo se llama la porción del capilar que sigue al asa de Henle al interior de la médula?
Vasa recta

El 80% de las nefronas son tipo ______, y el 20% de las nefronas son tipo ______
- Cortical
- Yuxtamedular
Nefronas que tienen asa de Henle más prominente
Se encarga de:
Nefronas yuxtamedulares
Concentrar más la orina
Zona renal con osmolaridad elevada
Mecanismo que eleva la osmolaridad
Médula
Mecanismo de contracorriente por asa de Henle y vasos rectos
Proceso en el que el agua y solutos de la sangre dejan el sistema vascular a través de la barrera de filtración
Ingresan a:
Filtración
Ingresan al espacio de Bowman
Proceso en el que pasan sustancias desde la luz a través de la capa epitelial hacia el intersticio circundante
Reabsorción
Proceso de desplazamiento de las sustancias hacia la luz tubular desde el citosol de las células epiteliales que forman las paredes de la nefrona
Secreción
Proceso donde se hace salir una sustancia del cuerpo
Excreción
Proceso que se encarga de pasar sustancias desde el filtrado glomerular hasta la sangre
Reabsorción
Proceso de desplazamiento de las sustancias desde la sangre hacia el filtrado glomerular
Secreción
- Ejemplo de sustancia con excreción fraccional > 1
- Ejemplo de sustancia con excreción fraccional < 1
- Creatinina
- Glucosa

¿Cómo se produce el filtrado glomerular?
Depende de:
Proceso inicia en la arteriola aferente que vierte su contenido a la cápsula de Bowman
Depende de: tamaño, carga y presión intraglomerulares

El filtrado glomerular posteriormente continua al:
Túbulo contorneado proximal
Tamaño requerido para que filtren sustancias a través de la barrera de filtración glomerular
Tamaño de la albúmina
7000 daltons
66000 daltons
¿Por qué las moléculas con carga negativa se filtran menos que las positivas?
Las membranas están cubiertas de carga negativa y repelen a moléculas negativas
La carga negativa solo afecta a:
Macromoléculas
Iones como bicarbonato se filtran fácil
¿Qué son las fuerzas de Starling?
Suma algebraica entre las presiones hidráulicas y las presiones oncóticas dentro del líquido que actúan en contra de sí mismas
Constitución de la triple membrana de filtración
- Primera barrera: orificios capilares
- Segunda barrera: membrana basal glomerular
- Tercera barrera: podocitos
Tinción más común para ver riñón en microscopio de luz
Tinciones auxiliares
H&E
PAS, Masson y Metenamina de plata